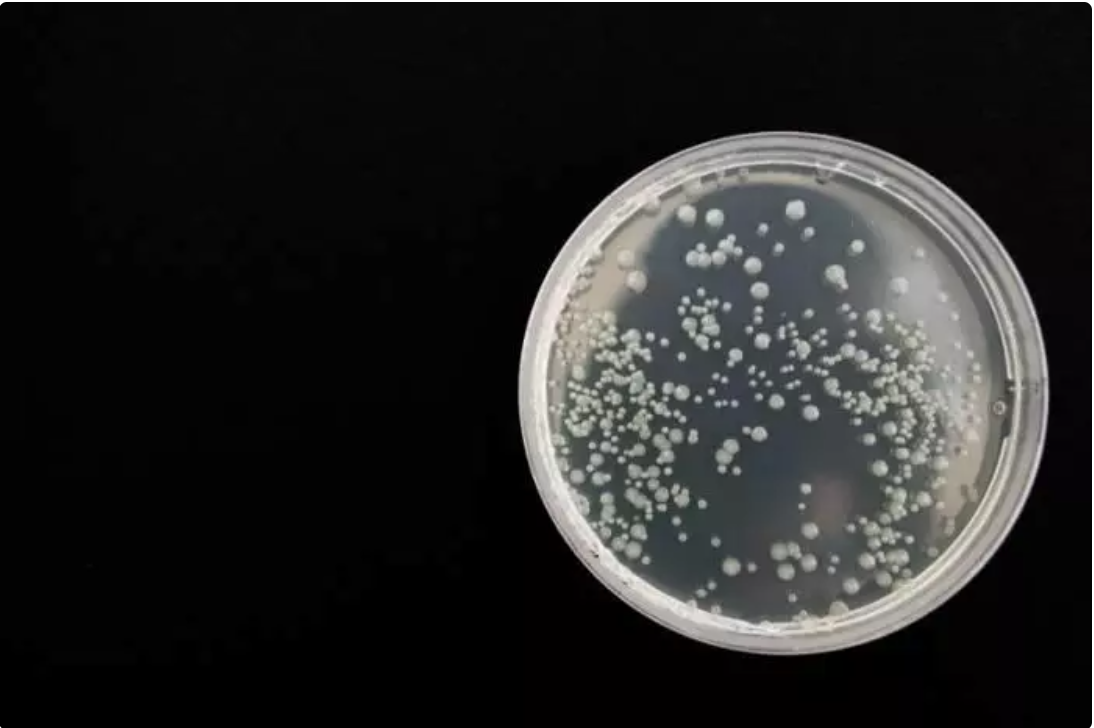
terminos esenciañes biologia

¿Necesitas ampliar tu vocabulario para estudiar Biología?
Como hemos descubierto, la Biología es una materia muy amplia que abarca una gran cantidad de temas. Como tal, también hay una gran cantidad de terminología que hay que entender.
Pero ¿qué pasa si solo planeas estudiar Biología en la ESO y luego quieres pasar a un área de estudios completamente diferente? ¿Tienes que esforzarte para aprender mucha terminología científica, aunque nunca la vuelvas a usar?
Dado que la biología es la ciencia de la vida y, por lo tanto, nos enseña todo lo relacionado con los seres humanos, así como sobre nuestro entorno, es probable que te encuentres con terminología básica de biología durante tu vida diaria, por lo que te resultará muy útil aprender este vocabulario clave.
Además, al comprender la terminología esencial de la biología, te resultará mucho más fácil comprender nuevas palabras y términos biológicos si decides continuar con tus estudios en este ámbito.
Sin embargo, dado que somos conscientes de que no todo el mundo aspira a estudiar Biología más allá del instituto, nos centraremos principalmente en lo esencial, comenzando con los temas que estudiarás en la ESO y Bachiller.

Sin embargo, en este nivel básico, seguramente te darás cuenta de que el lenguaje que al principio pensaste que era un poco desconcertante en realidad no es tan difícil.
¿Quieres una clase biologia?
Términos esenciales para Biología de la ESO y Bachiller
Para hablar del vocabulario esencial de Biología, tenemos que fijarnos en los temas que se tratan durante los años de la ESO y Bachiller. ¡Con suerte, al final de este artículo, te gustará más la asignatura!
Durante estos años estudiarás una variedad de temas prácticos y evaluativos, diseñados para responder a esta gran pregunta: ¿Cómo funciona la ciencia?
La asignatura se basa en una serie de temas relacionados con el mundo natural y relevantes para los estudiantes. Está diseñado para ayudarlos a comprender cómo se puede utilizar la ciencia para explicar el mundo en el que viven y el impacto que los humanos tienen en él.
Aquí tienes algunos de los términos que te serán útiles en tus clases de Biología.
Biología Celular
La biología celular es el estudio de la estructura y función de las células, explorando el concepto de que la célula es la unidad fundamental de todos los organismos vivos. El término engloba las características de una célula, es decir, los tejidos y organismos que compone cada una. Dado que la célula es la unidad más pequeña de un organismo vivo, estos componentes básicos de la vida deben examinarse con un microscopio.
Organización
Organización es un término biológico que se utiliza para describir la jerarquía de estructuras y sistemas biológicos. Las plantas y los animales tienen diferentes tipos de células que comparten algunas estructuras similares. Los científicos usan el término con un enfoque reduccionista, lo que significa que los niveles en el cuadro jerárquico representan un aumento en la complejidad organizacional basado en la unidad básica del nivel anterior.
Infección
Seguro que reconoces esta palabra que es bastante familiar para la mayoría de las sociedades. Describe el proceso o estado en el que un agente infeccioso invade los tejidos del organismo anfitrión y se multiplica, desarrollando una enfermedad o dolencia. Los agentes infecciosos, que normalmente no se encuentran en el cuerpo, pueden ser virus, bacterias o parásitos.
¿Buscas clases de biologia para secundaria?
Bioenergética
La bioenergética se ocupa de la química y la biología simultáneamente y analiza la energía que crea y rompe los enlaces químicos en las moléculas que se encuentran en los organismos vivos.
Homeostasis
La homeostasis es un término que hace referencia a la capacidad de una célula o grupo de células para buscar y mantener un estado estable cuando se enfrenta a cambios externos. Se usa comúnmente para describir las funciones de partes del cuerpo como el riñón, el hígado y la piel, cada una de las cuales se esfuerza por mantener un ambiente interno constante independientemente de a qué se enfrente el cuerpo externamente.
Herencia
Como término biológico, «herencia» significa el proceso de transmisión genética de características de padres a hijos.

Variación
La variación, en términos biológicos, se refiere a cualquier diferencia entre células, organismos o grupos de organismos causada por la variación genotípica. También puede indicar cualquier diferencia causada por factores ambientales, específicamente llamada variación fenotípica.
Evolución
La evolución es el cambio natural en las características hereditarias de los organismos vivos durante generaciones consecutivas. Por lo general, hay un cambio en los genes de una población de una generación a la siguiente, como resultado de una mutación, deriva genética o selección natural. La razón de tal evolución es que el organismo se adapta físicamente o en el comportamiento.
Ecología
La ecología es una rama de la biología que se ocupa de las relaciones entre los organismos y su entorno físico. El campo interdisciplinario incluye aspectos de Biología y Geografía.
Vocabulario contemporáneo
Hay científicos que no creen que las clases reflejen los nuevos avances en biología.
Los avances en tecnología están cambiando continuamente lo que somos capaces de hacer y descubrir, no solo en el mundo de la ciencia, por lo que es inevitable que esta era tecnológica moderna haya tenido una gran influencia en la Biología en los últimos años, como demuestran los avances más importantes en biología.
De hecho, la biología molecular moderna se basa en gran medida en las nuevas tecnologías. Sin embargo, los componentes tecnológicos de los cursos de Biología apenas han cambiado en las últimas décadas.
Los científicos creen que los cursos de biología moderna, si quieren realmente animar a los jóvenes biólogos y darles una visión real de la ciencia tal como existe hoy en día, deberían actualizar las clases y hacerlas más relevantes para la disciplina.
Aunque parece que la Física está creciendo conforme avanzan los tiempos, los profesionales del sector de la Biología no sienten que su campo de estudio tenga el mismo nivel de sofisticación dentro de la educación y, por lo tanto, no se les dan los conceptos básicos necesarios para comprender realmente cosas como la alineación de secuencias de ADN o los algoritmos de predicción de genes.

Estos conceptos, que se describen como bioinformática, son importantes para los biólogos contemporáneos y, por lo tanto, también lo es el vocabulario relacionado con ellos.
¿Dónde encontrar más vocabulario y glosarios?
Si te interesa descubrir más palabras relacionadas con la biología y sus definiciones, ¿por qué no recurres primero a tu libro de texto para obtener ayuda? La mayoría de los libros de texto de ciencias incluirán un glosario de términos que puedes usar para repasar para tus exámenes o simplemente para estar al tanto del complejo lenguaje que surge durante cada lección.
Alternativamente, si buscas una lista mucho más amplia de términos biológicos, puedes encontrar muchas listas de vocabulario en Internet. En el sitio de curtisbiologia.com, por ejemplo, encontrarás una lista muy extensa de términos de biología y es una fuente de material actualizado a la luz de los nuevos enfoques, investigaciones y problemas sobre los que trabajan los biólogos en el presente.
En otras páginas como la de la Academia Gauss de Zaragoza o la del Colegio Maravillas de Benalmádena, también encontrarás listas muy completas de términos relacionados con la biología. ¡Solo tienes que poner en Google «vocabulario de biología» para encontrarlas!
¿Y si también accedes a la página de la Fundación Nobel para descubrir cuáles han sido los últimos descubrimientos en biología?
¿Cómo puede un profesor particular ayudarte con el vocabulario esencial?
Si tienes dificultades en biología y crees que un poco de ayuda en biología de la ESO o Bachiller podría ayudarte a reducir un poco la presión de los exámenes, ¿por qué no recurres a un profesor particular de biología que pueda repasar la terminología clave contigo todas las semanas y te ayude a crear tarjetas de memoria que contengan el vocabulario esencial?
Aunque un buen profesor particular de biología cualificado puede ser un poco caro, es dinero bien invertido si eso significa que completas tu curso con una buena nota o incluso logras obtener una nota más alta de lo que te podías imaginar. También puedes optar por las clases online de biología, que pueden ser más baratas, ya que son más flexibles.









